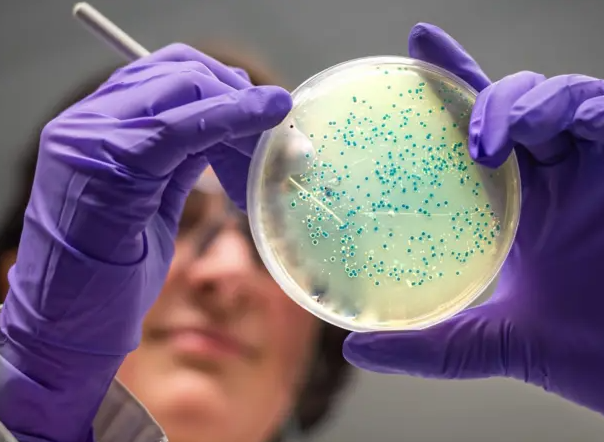
Vještačka inteligencija pronašla antibiotike za gonoreju i MRSA superbakterije

Vještačka inteligencija osmislila je dva nova potencijalna antibiotika koja bi mogla zaustaviti infekcije izazvane MRSA bakterijom i gonorejom otpornom na lijekove, otkrili su naučnici.
Lijekove je, atom po atom, dizajnirala vještačka inteligencija, a pokazali su se učinkovitim protiv superbakterija u laboratorijskim uslovima i kroz testiranja na životinjama.
Ipak, ova jedinjenja zahtijevaju godine usavršavanja i kliničkih ispitivanja prije nego što bi mogla biti prepisivana pacijentima.
Tim sa Massachusetts Institute of Technology (MIT), koji stoji iza otkrića, smatra da bi vještačka inteligencija mogla označiti početak„drugog zlatnog doba“ u otkrivanju antibiotika.
Antibiotici uništavaju bakterije, ali infekcije koje su otporne na liječenje sada uzrokuju više od milion smrtnih slučajeva godišnje.
Pretjerana upotreba antibiotika pomogla je bakterijama da evoluiraju i postanu otporne na lijekove, dok se decenijama suočavamo s nedostatkom novih antibiotika.
Ranije su istraživači koristili vještačku inteligenciju kako bi analizirali hiljade poznatih hemikalija u pokušaju da pronađu one s potencijalom da postanu antibiotici.
Ovoga puta, MIT-ov tim otišao je korak dalje – koristili su generativnu vještačku inteligenciju za pronalazak novih antibiotika, posebno protiv seksualno prenosive infekcije gonoreje i potencijalno smrtonosne MRSA bakterije (meticilin-rezistentni stafilokokus aureus).
Studija, objavljena u časopisu Cell, analizirala je čak 36 miliona jedinjenja, uključujući i ona koja još ne postoje ili nisu otkrivena, piše BBC.
Naučnici su trenirali vještačku inteligenciju na osnovu poznatih hemijskih struktura, zajedno s podacima o tome kako utiču na rast različitih bakterija.
AI je tako naučila kako različite molekularne strukture, sastavljene od ugljika, kiseonika, vodonika i azota, djeluju na bakterije.
Dva pristupa su primijenjena u dizajniranju antibiotika – jedan je počinjao od biblioteke hemijskih fragmenata i gradio dalje, a drugi je davao AI potpunu slobodu od samog početka.
Proces je eliminisao sve što je izgledalo previše slično postojećim antibioticima ili što bi moglo biti otrovno za ljude.
Nakon laboratorijskih ispitivanja i testiranja na zaraženim miševima, naučnici su došli do dva potencijalna nova lijeka.
„Uzbuđeni smo jer pokazujemo da se generativna vještačka inteligencija može koristiti za dizajniranje potpuno novih antibiotika“, rekao je profesor James Collins sa MIT-a za BBC.
„AI nam može omogućiti da brzo i jeftino osmislimo molekule i time proširimo naš arsenal, dajući nam prednost u borbi našeg uma protiv gena superbakterija.“
Međutim, lijekovi još nisu spremni za klinička testiranja i zahtijevat će dodatno usavršavanje.
Procjenjuje se da će biti potrebno godinu do dvije prije početka testiranja na ljudima.
Dr. Andrew Edwards s Imperial Collegea u Londonu ocijenio je ovaj rad „veoma značajnim“ i s „ogromnim potencijalom jer predstavlja novi pristup otkrivanju antibiotika“.
Ipak, upozorio je da i dalje predstoji težak posao testiranja sigurnosti i učinkovitosti, što je dug i skup proces bez garancije da će lijekovi ikada doći do pacijenata.
Profesor Collins naglasio je da su „potrebni bolji modeli“ koji ne testiraju samo djelovanje u laboratoriji, već i vjerodostojnu efikasnost u ljudskom tijelu.
Još jedan izazov je masovna proizvodnja AI otkrića– od 80 najboljih teorijskih tretmana za gonoreju, samo dva su uspjela biti sintetizovana.
Profesor Chris Dawson s Univerziteta u Warwicku kazao je da je studija „odlična“ i da pokazuje kako je vještačka inteligencija „značajan korak naprijed kao alat za otkrivanje antibiotika i ublažavanje problema rezistentnosti“.
Ipak, dodao je, ekonomski problem ostaje: „Kako razvijati lijekove koji nemaju komercijalnu vrijednost?“
Naime, novi antibiotici bi se, u idealnom slučaju, koristili što rjeđe kako bi se sačuvala njihova efikasnost – što istovremeno otežava ostvarivanje profita.
(Vijesti.ba)